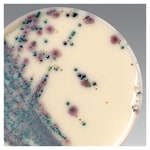

Search
- Home
- Shop All Products
- Freeze Dried Supplementary Reagents

Oxoid™ ONE Broth-Salmonella Supplement
Thermo Scientific™ Oxoid™ ONE Broth-Salmonella Supplement is for the selective enrichment of Salmonella spp. from food samples in 24 hours in a single enrichment step.

Oxoid™ Brilliance™ 李斯特菌鉴别添加剂
在 Brilliance 李斯特菌琼脂基础(生产编号:CM1080E 和生产编号:CM1080B,一种显色培养基)中添加 Oxoid Brilliance 李斯特菌鉴别添加剂,用于分离和区分李斯特菌